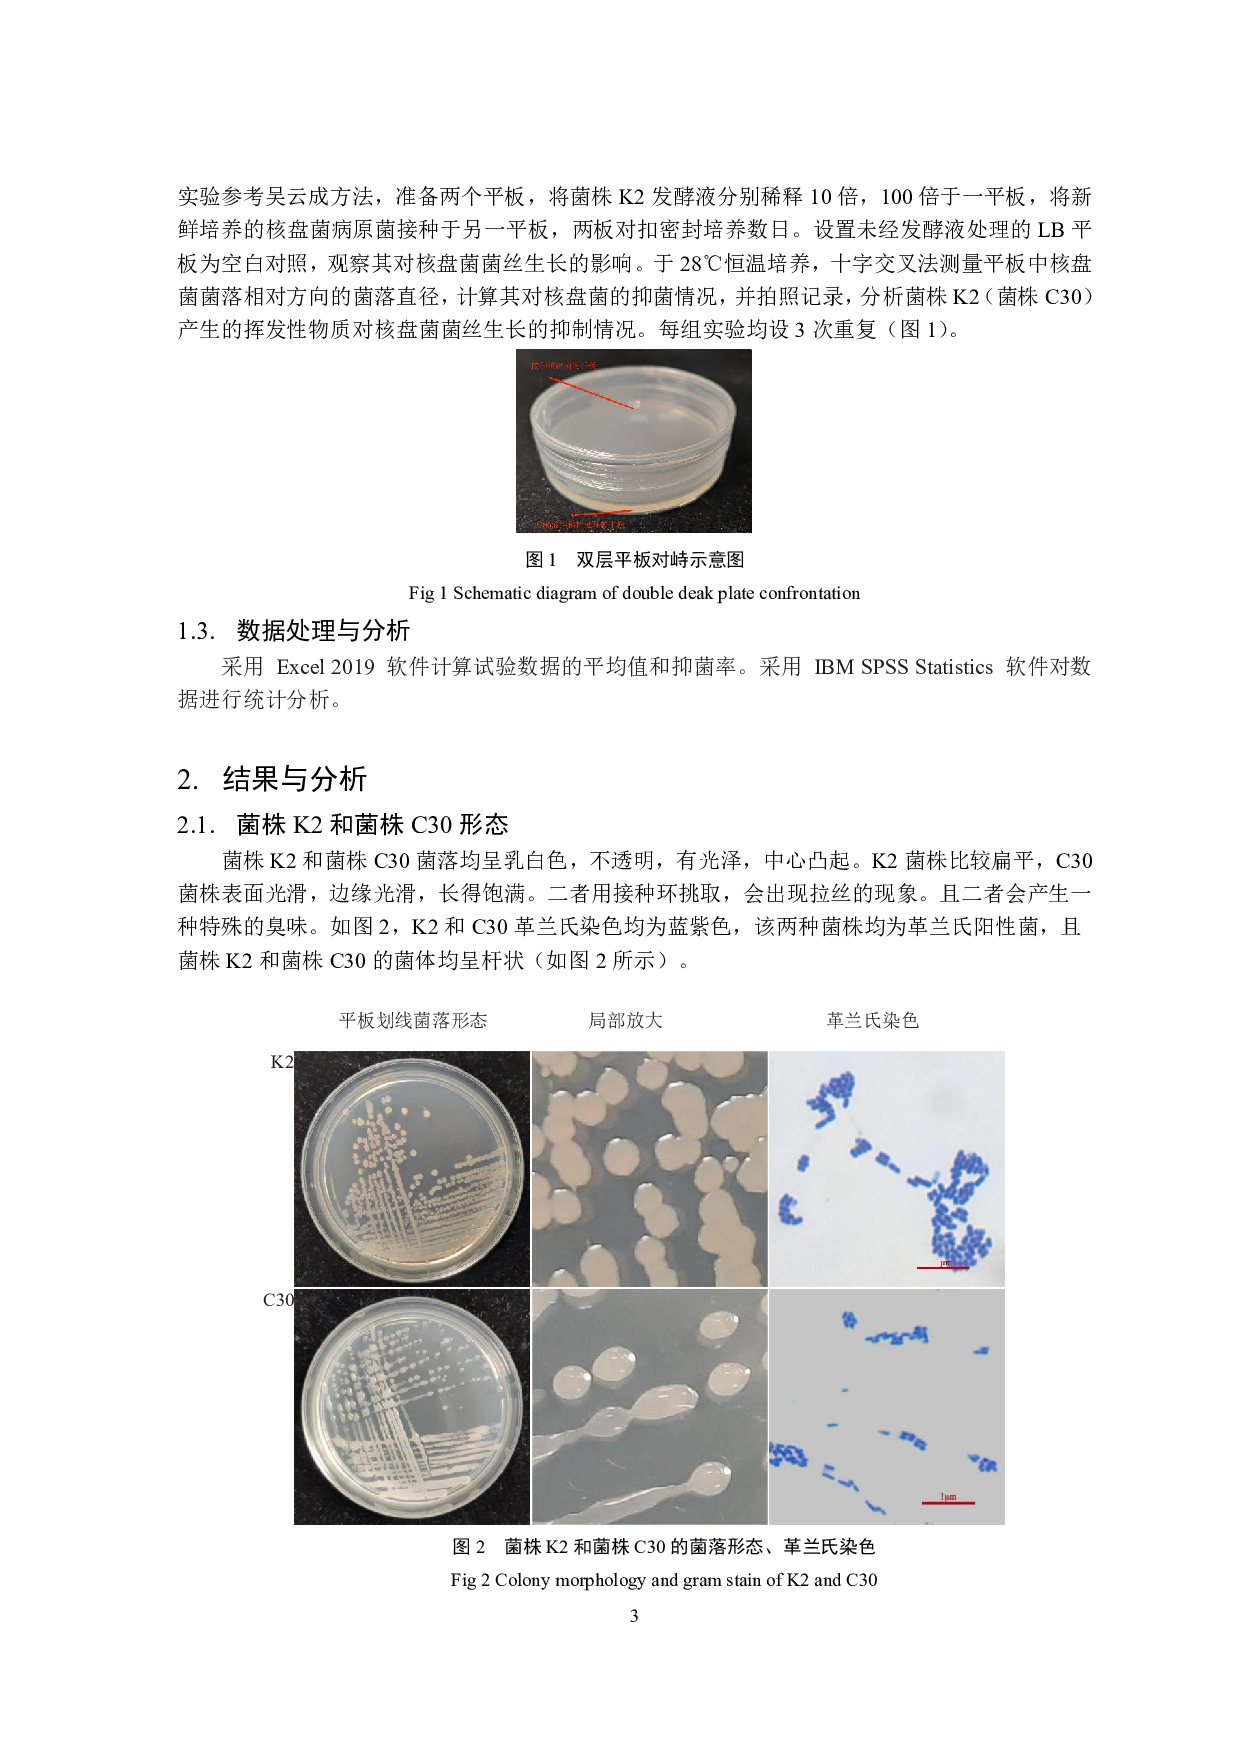
核盘菌拮抗菌生防作用的初步探究-7601字.pdf 第4页

目录
摘要..............................................................................................................................................................1
关键词..........................................................................................................................................................1
1.材料与方法...............................................................................................................................................2
1.1.试验材料
核盘菌拮抗菌生防作用的初步探究-7601字.pdf